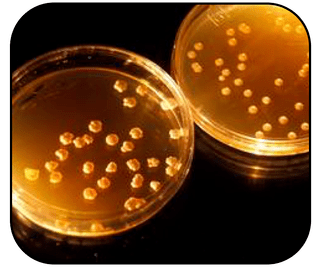

GCD Projects
GCD’s efforts are focused on the mid Technology Readiness Level (TRL) range of 3 to 5 or 6, generally taking technologies from initial lab concepts to a complete engineering development prototype. Learn more about Game Changing Development featured projects.
Each technology project within the Game Changing Development Program focuses on advancing capabilities for going to and living in space.
Game Changing Development projects aim to advance space technologies that could lead to new approaches for the agency’s future space missions and provide solutions to significant needs.
About GCDGO.
These space technology projects aim to enable rapid, safe and efficient travel for future missions. “GO” technologies will help facilitate low-cost delivery of robotic payloads to the Moon, Mars and beyond. Several projects focus on reducing mission costs and complexity by advancing reusable launch and in-space propulsion systems. Other projects in this area are advancing in-situ resource utilization (ISRU) technologies for creating propellants in space. Among others, some “GO” technology projects in the Game Changing Development portfolio include: An advanced thruster engine design that uses propellants capable of operating at extremely low temperatures for an extended period of time without freezing. Lighter rocket hardware pieces that could substantially reduce the fabrication time and cost of rocket thrust chamber assemblies. High-power hall thrusters for Mars nuclear electric propulsion.

Thruster Advancement for Low-temperature Operation in Space
Learn how Thruster Advancement for Low-temperature Operation in Space (TALOS) provides rapid, safe, and efficient space transportation.

Rapid Analysis and Manufacturing Propulsion Technology
Learn how Rapid Analysis and Manufacturing Propulsion Technology (RAMPT) provides rapid, safe, and efficient space transportation.

Composite Technologies for Exploration
Learn how Composite Technologies for Exploration (CTE) provides rapid, safe, and efficient space transportation.
LAND.
“LAND” projects aim to expand access to diverse planetary surface destinations. These technologies will enable lunar and Mars access in order to land large payloads to support human missions. The “LAND”-focused developments in the GCD portfolio include: A suite of landing technologies that will enable future Moon missions to target landing sites that weren’t possible during the Apollo missions, such as regions with hazardous boulders and shadowed craters. Instruments on the Perseverance rover that will measure the pressure and heat on the Mars 2020 entry vehicle’s backshell, an area with minimal pressure flight data and no heating flight data. Modeling and testing capabilities to better understand how rocket exhaust plumes affect a landing site.

Plume Surface Interaction
Learn how Plume Surface Interaction (PSI) expands access to diverse surface destinations.

Entry System Modeling
Learn how Entry System Modeling (ESM) expands access to diverse surface destinations.

Safe Precise Landing Integrated Capabilities Evolution
Learn how Safe and Precise Landing — Integrated Capabilities Evolution (SPLICE) expands access to diverse surface destinations.
LIVE.
“LIVE” projects enable humans to live and work farther away from Earth. These projects will conduct human and robotic lunar surface missions beyond 28 days without resupply, and conduct human Mars missions beyond 800 days including transit without resupply. The projects help to enable surface habitats that use local resources to create a variety of valuable items, such as propellant and water. Among others, some “LIVE” technologies within the GCD portfolio include: The capability to manufacture and repair parts on-demand in space. A platform for producing nutrients on-demand during deep space missions A software system that could eventually enable astronauts on long-duration missions to diagnose and treat emergency conditions quickly, rather than waiting on delayed expert medical advice from ground support .

Bulk Metallic Glass Gears
Learn how Bulk Metallic Glass Gears (BMGG) sustain living and working farther from Earth.

Cold Operable Lunar Deployable Arm
Learn how the Cold Operable Lunar Deployable Arm (COLDArm) sustains living and working farther from Earth.

Integrated System for Autonomous and Adaptive Caretaking
Learn how the Integrated System for Autonomous and Adaptive Caretaking (ISAAC) sustains living and working farther from Earth.

Infrastructure Pilot Excavator
Learn how the Infrastructure Pilot Excavator (IPEx) sustains living and working farther from Earth.

Polar Resources Ice Mining Experiment – 1
Learn how the Polar Resources Ice Mining Experiment-1 (PRIME-1) sustains living and working farther from Earth.

SpaceCraft Oxygen Recovery
Learn how SpaceCraft Oxygen Recovery (SCOR) sustains living and working farther from Earth.
Space Synthetic Biology
Learn how Space Synthetic Biology (SynBio) sustains living and working farther from Earth.

Superlightweight Aerospace Composites
Learn how Superlightweight Aerospace Composites (SAC) sustain living and working farther from Earth.
EXPLORE.
“EXPLORE” projects support transformative missions and discoveries at the Moon, Mars and other extreme space environments. The space technologies developed in this area will enable architectures that are more rapid, affordable and capable than ever before. NASA’s EXPLORE projects are developing new approaches for in-space servicing, assembly and manufacturing. These projects take space data processing to the next generation with higher-performance computing, communications and navigation. Among others, the “EXPLORE”-focused technologies in the GCD portfolio include: Shoebox-sized robots to autonomously scout regions on the Moon and gain intel about locations that may be difficult for astronauts to investigate on foot, like hard-to-reach craters and narrow caves. A payload that will significantly improve the utility for lunar landers by providing manipulation capabilities through the lunar night by using novel Bulk Metallic glass gears. A system that could unpack and assemble into an antenna or small habitat on its own.

Cooperative Autonomous Distributed Robotic Exploration
Learn how Cooperative Autonomous Distributed Robotic Exploration (CADRE) transforms missions and discoveries.

High Performance Spaceflight Computing
Learn how High Performance Spaceflight Computing (HPSC) transforms missions and discoveries.

Distributed Spacecraft Autonomy
Learn how Distributed Spacecraft Autonomy (DSA) transforms missions and discoveries.

Automated Reconfigurable Mission Adaptive Digital Assembly Systems
Learn how Automated Reconfigurable Mission Adaptive Digital Assembly Systems (ARMADAS) transform missions and discoveries.







